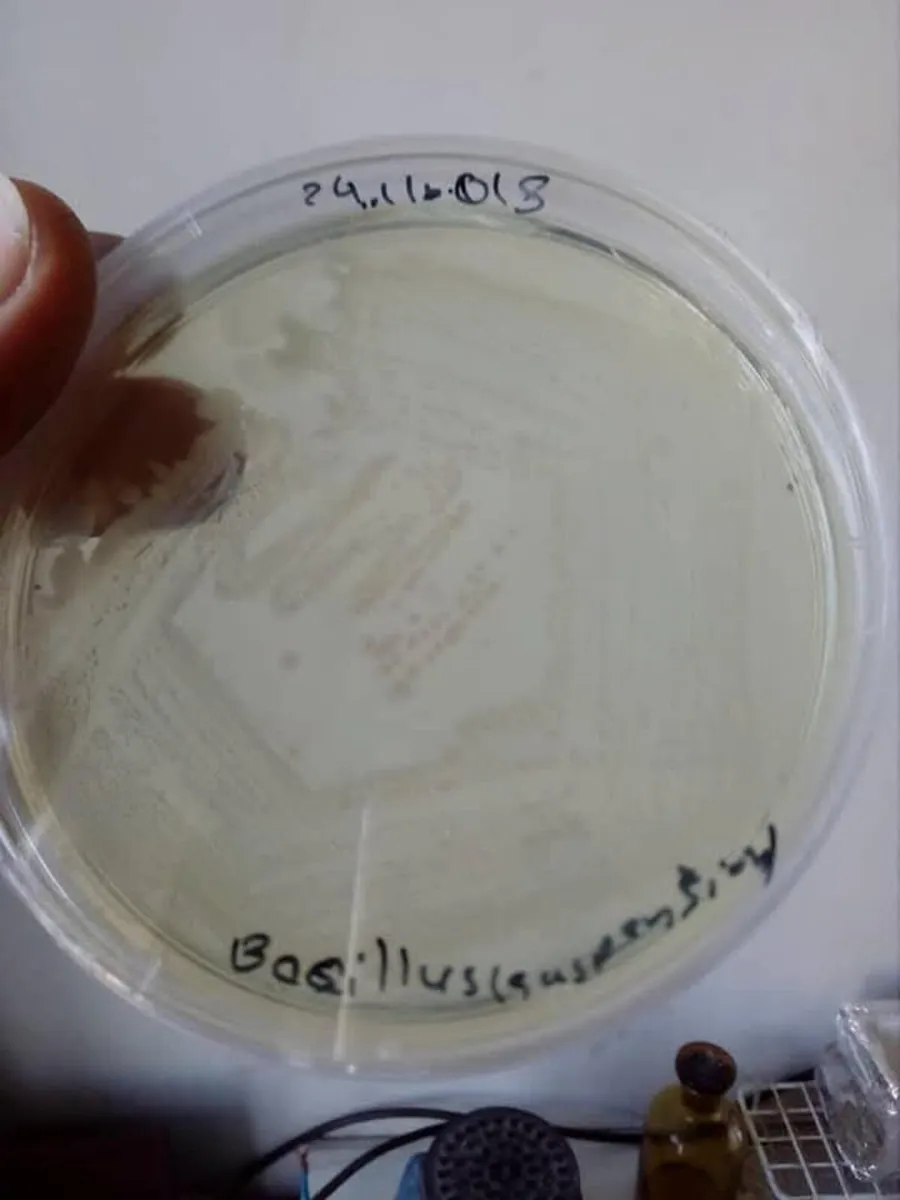
Liquid Bio Stimulator - Image 2
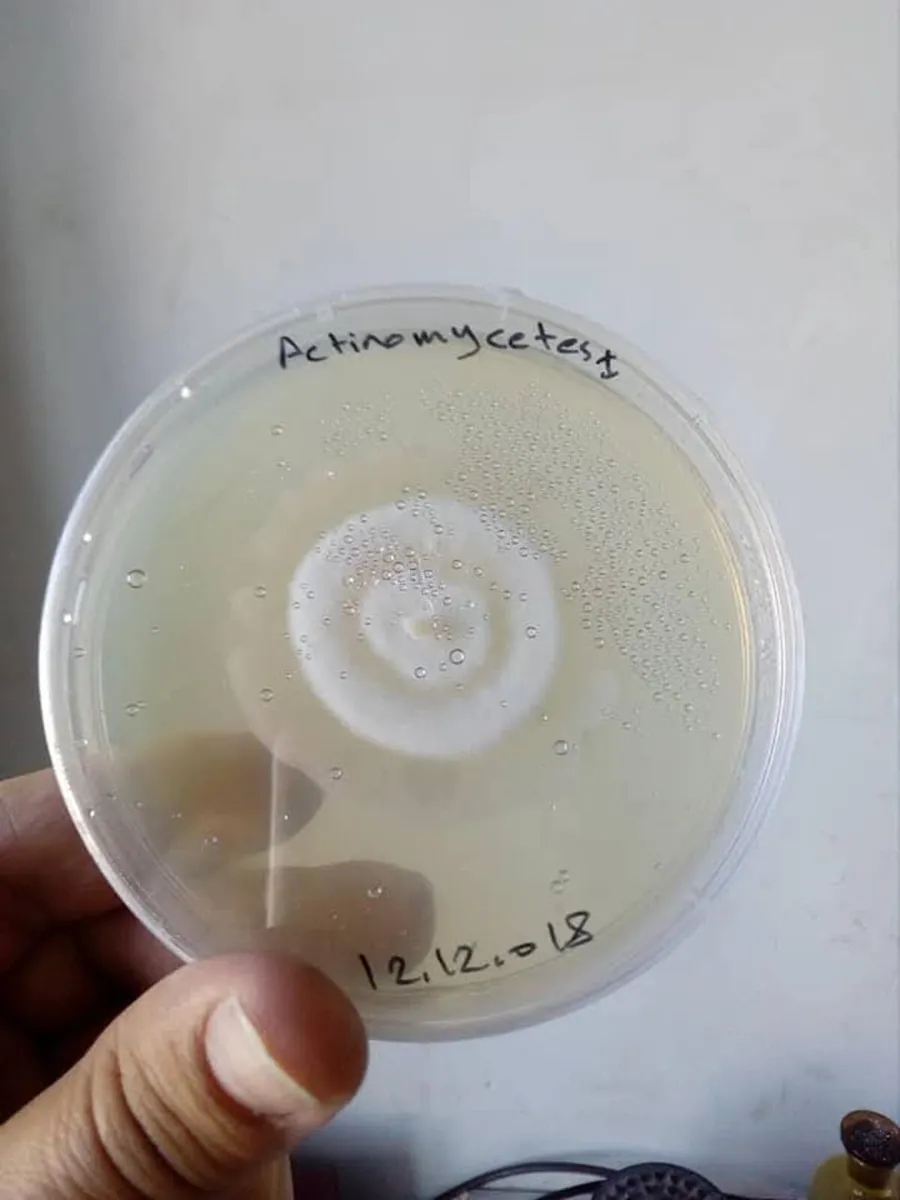
Liquid Bio Stimulator - Image 4

Liquid Bio Stimulator
- 2 hours
- 23 views
- Nenagh, Tipperary
Description
CHAP LIQUID BIO PLANT BOOSTER . Liquid Bio-Stimulant 100% NATURAL • ORGANIC • HIGH PERFORMANCE BOOST YOUR SOIL – SEE THE DIFFERENCE Why Use CHAP LIQUID ? ✔ Stronger root growth ✔ Better nutrient uptake ✔ Healthier soil biology ✔ Improved crop & grass yields Enriched with Naturally Occurring: Trichoderma Bacillus megaterium Actinomycetes Bacillus spp. Bio Carbon Humic & Fulvic Acids Details 3L Bottle – €29 Mix with 150L water or slurry Covers approx. ½ acre Limited Availability Only ~2000 litres are available (No bulk orders – first come, first served) Collection / Delivery 📍 Ballina – Killaloe, Co. Tipperary ✔ Collection preferred ✔ Postage available (buyer covers fees) Contact WhatsApp/Text: +353 85 156 9122 Text me on what's app ,please .
Some information displayed may be provided by third parties or identified using AI, and may not be fully accurate, complete, or up to date.
![[object Object] image](https://statics.donedeal.ie/dist-marketplace-frontend-donedeal/2026.4.27-153328.production/spassets/images/illustrations/profile-new.svg)
0851569122
- Verified Private Seller
- Nenagh, Tipperary
Email, Phone, Payment card
No rating
0
No reviews yet
4 years
on DoneDeal
DoneDeal Rating
This seller does not have a rating yet.
Find out how we are keeping you safe.
Learn MoreLegal
DoneDeal.ie is not responsible for the advertised goods. It is illegal to use the contact information for commercial purposes.
![[object Object] image](https://statics.donedeal.ie/dist-marketplace-frontend-donedeal/2026.4.27-153328.production/spassets/images/illustrations/profile-new.svg)
- Verified Private Seller
- Tipperary
Email, Phone, Payment card
No rating
0
No reviews yet
4 years
on DoneDeal
Tips and Guides
- Safety Guide
- Be informed, read our advice if you get unwanted calls






